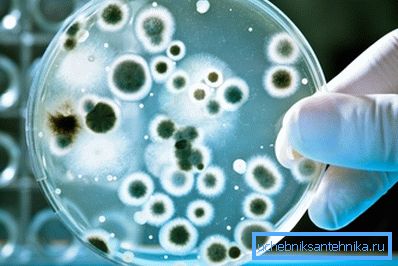

Veden desinfiointi kaivossa: kertaluonteiset ja
Jos sinulla on epäilyksiä vesilähteen puhtaudesta tai jos vesistöjen tutkiminen osoitti, että kontaminaatiotaso ylittää sallitut normit, on kiireesti harkittava desinfiointia. Tällöin puhdistus on suoritettava säännöllisesti, ja joissakin tapauksissa desinfiointi on suoritettava vähintään kerran viikossa.
Artikkelissamme kerrotaan, miten päästä eroon patogeenisistä mikrobeista, miten pehmentää vettä kaivosta, ja myös mitä on tehtävä lähteen normaalin terveyden ylläpitämiseksi.

No kunnon arviointi
Nesteen laadun parametrit
Jos aiot käyttää jo varustettua lähdettä, on ensinnäkin selvitettävä, onko mahdollista juoda vettä kaivosta, helpoin tapa haastatella naapureitamme: jos maanalaisia vesiä käytetään viereisillä alueilla, eikä kukaan ole myrkytetty vielä, perusmahdollisuus on olemassa. .
Nyt on tehtävä alustava analyysi.
Jos et tiedä, mistä tarkistat veden laadun kaivosta tai et halua käyttää rahaa, voit tehdä "kansan korjaustoimenpiteitä":

- Helpoin tapa - kontrolloida teetä. Valitsemme kaivosta vettä ilman suodatusta ja laskeutumista ja voimakasta mustaa teetä. Ohjausosa valmistetaan pullotetulla vedellä, jossa on alhainen suolapitoisuus tai tuotu suodatettu vesi. Jos ero on hyvin havaittavissa, puhdistusta tarvitaan.
- Myös kaivon veden laadun tarkistaminen mahdollistaa asettelun pimeässä paikassa.. Kaada vettä suljettuun astiaan ja aseta esimerkiksi kaappiin. Huono neste 48 tunnin kuluttua saostuu tai öljyinen kalvo veden pinnalle.
- Nopea mineralisointitesti peilillä. Laitamme lasille joitakin tippoja ja odotamme kuivumista. Valkoinen ja vielä pahempi - likainen-ruskea avioero on hyvin häiritsevä signaali.
- Kaivopermanganaatilla olevan veden tutkiminen auttaa määrittämään orgaanisen aineen määrän. Jos kaliumpermanganaatin vaaleanpunainen liuos muuttuu nopeasti keltaiseksi, sinun ei pidä käyttää nestettä ennen puhdistusta.
Ja jos et tiedä, miten veden laatua voidaan tarkistaa, on parempi ottaa yhteyttä esimerkiksi ammatillisiin palveluihin SES: ssä. Tällaisen valvonnan kustannukset ovat tietenkin melko korkeat, mutta saat kaikkein tärkeimmän kuvan.
Työohjelma
Niinpä suoritetaan alustava tai laboratorio-ohjaus ja vesi tunnistetaan pääasiassa soveltuvaksi desinfioinnin jälkeiseen juomiseen. Mitä meidän on tehtävä?
Vedenkäsittelyn työsuunnitelma sisältää seuraavat vaiheet:
- Suorita korjaustöitä, jotta saostuminen, maaperän hiukkaset, vieraat esineet jne. Eivät pääse vesikerrokseen. Samaan aikaan me vedenpitävät kotelon sisä- ja ulkopuolelta, rakennamme sokean alueen, varmistamme kannen tiiviyden jne.
Kiinnitä huomiota! Kaulan kansi on varastoitava, vaikka katto peittäisi kaivon.
- Kaivoksen seinien puhdistus mineraaliesiintymistä, levistä, bakteerien ja sienien pesuista.

- Sylinterin poistaminen pohjasta (vedenpoisto ja / tai mekaaninen menetelmä).
- Kaivos, puhdistus ja pohjakalan suodattimen asettaminen.
- Käytettyjen seinien ja laitteiden desinfiointi.
- Vesien suoran desinfioinnin toimenpiteet.
Tietyn taidon läsnä ollessa tämä suunnitelma voidaan toteuttaa omin käsin. Näin voimme vähentää kustannuksia merkittävästi, koska kun otat yhteyttä siivoukseen erikoistuneeseen yritykseen, sinun on maksettava huomattava määrä.
Vihje! Jos etsit, mistä tarkistat veden kaivosta tai kuka ottaa yhteyttä desinfiointiin, älä missään tapauksessa pysähdy alimmalla hinnalla. Jos desinfioinnin yhteydessä ei ole ongelmia, analyysin tarkkuus ei selvästikään ole parhaimmillaan. Ammattilaisten laitteiden kattava tutkimus voi maksaa noin 5-8 tuhatta ruplaa.
suoritetaan desinfiointi
Puhdistus ja desinfiointi
Kuten suunnitelmasta käy ilmi, todellinen puhdistus on jaettu kahteen vaiheeseen: kaivon käsittely ja terveysolosuhteiden ylläpito. Seuraavassa tarkastellaan kaikkia tätä varten käytettyjä tekniikoita.

Ohjeita kaivon käsittelystä ovat tällaiset toimet:
- Ensinnäkin meidän on pumpattava vesi tai poistettava se, ja mieluiten aivan pohjaan. Tämä voidaan tehdä yksinkertaisimman pumpun avulla.
Vihje! Jotta estettäisiin pumpun, joka ei ole tarkoitettu viemäröintiin, tukkeutumasta pohjaan, kiinnitämme noin puolen metrin pituisen tangon pohjaan vedenottoaukon lähellä. Stick lepää pohjassa eikä anna pumpun "tarttua" hiekkaa ja lietettä.
- Kuivaan kuopan akseli mekaanisesti. Tätä varten laskeudumme alas ja kaavailemme sadan seinän kaiken, joka on kaavittu pois - suola-, bakteerilevy, levien pesäkkeet jne. Käsittelyn jälkeen meidän on säilytettävä puhtaat betonirenkaat hyvin.
- Seuraavaksi käymme itsellemme lapion ja keräämme pohjasta hiekan ja hiekan suodattimen ylemmän kerroksen. Köydellä olevan kauhan avulla nostamme kerätyn materiaalin pinnalle ja asetamme sen tasaiselle alueelle, joka on peitetty suojapeitteellä tai kuitukangasmateriaalilla.
- Lisää pesun jälkeen soraan tai silikoniin soraa. Nämä mineraalit auttavat pehmentämään vettä, mikä on myös erittäin tärkeää.

Vihje! Työn helpottamiseksi voit käyttää tyhjennyspumppua. Tällöin liete pumpataan ulos ilman kaivon alustavaa tyhjennystä.
- Tarkastamme kotelorenkaiden välistä aukkoa, kaikki havaitut ontelot laastarit tiivistetään.
Seuraavaksi aloita veden klooraus kaivossa:
- Laimenna kylmään veteen valkaisevaan aineeseen (20 grammaa kalkkia litraa vettä kohti tai 500 ml "valkoisuutta" kauhaa kohti).
- Tuloksena oleva koostumus levitetään kaivon seinämiin harjalla tai suihkemaalilla.

- Työn aikana meidän on käytettävä hengityssuojainta, ja kun on tarpeen laskeutua suurelle syvyydelle, sitten kaasunaamari.
- Jos koostumus pysyy - kaada se pohjalle. Joka tapauksessa, muutaman tunnin kuluessa vesi saapuu ja reaktio, jota tarvitsemme, kulkee.
- Suljamme kaivon polyeteenillä vähintään kaksi päivää.
- Tämän ajan kuluttua avaa kansi, tuuleta akseli ja huuhtele seinät letkulla.
- Kerätty vesi pumpataan ulos ja tyhjennetään. Sitä voidaan käyttää vain teknisiin tarkoituksiin: se ei sovellu juomiseen tai kasteluun.
Pumppauksen jälkeen on tarpeen tarkistaa nesteen koostumus: jos se vielä antaa valkaisuaineita, pumppaus on toistettava. On myös suositeltavaa keittää vettä vähintään kaksi viikkoa ennen juomista.
Säilytä hyvä terveys
Jos analyysit osoittavat, että ponnisteluistamme huolimatta saastumisaste on sallitun tason yläpuolella, meidän on valmisteltava järjestelmällisesti itse vesi.

Vihje! Alla kuvatut toimenpiteet ovat merkityksellisiä myös epidemiologisten uhkien kannalta.
Se tehdään näin:
- Jos etsit tapa desinfioida vettä hyvin, niin helpoin tapa on käyttää valkaisuaineita. Tätä varten laskemme vesisäiliön likimääräisen tilavuuden litroina (tämä on helppo tehdä, jos veden peilin taso on tiedossa).
- Lisätään saadun tilavuuden perusteella veteen 2 - 5 milligrammaa aktiivista klooria litrassa vettä. Yleensä laadultaan desinfiointia varten on riittävästi litraa valkaisuliuosta (1%).
- Reagenssin lisäämisen jälkeen vesi on sekoitettava huolellisesti ja vasta sitten sen valintaan. Hyviä tuloksia saavutetaan ilmastimella: nesteen kyllästyminen hapella lisää kloorin aktiivisuutta ja levitetyn liuoksen määrää voidaan pienentää ainakin kahdesti.

- Valkaisun sijasta voidaan käyttää myös kaliumpermanganaattia tai erityisiä desinfiointiaineita. Ne ovat helppokäyttöisiä (ei tarvitse kärsiä halutun pitoisuuden liuoksen valmistuksessa), mutta niiden hinta on erittäin korkea. Jos sinulla on kuitenkin varaa siihen - osta turvallisesti!
Kiinnitä huomiota! Samanlaisia yhdisteitä voidaan käyttää lievittämään liian kovaa vettä.
Joka tapauksessa on välttämätöntä jatkuvasti seurata veden laatua, ja tarvittaessa suoritettava täydellinen puhdistus välittömästi.
johtopäätös
Tiedot siitä, miten vesi desinfioidaan kaivossa, ovat hyödyllisiä maaseudun omistajille. Jos suoritat edellä kuvatut menettelyt vähintään kerran kahdessa kolmessa vuodessa, sinulla ei varmasti ole ongelmia veden laadun kanssa, samoin kuin levien kasvun ja levien kasvun kanssa. Saat lisää hyödyllisiä vinkkejä katsomalla videon tässä artikkelissa.